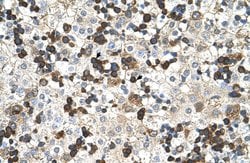
Invitrogen HBZ Polyclonal Antibody 100 &mu;L; Unconjugated:Antibodies,

missing translation for 'onlineSavingsMsg'
Learn More
Learn More
Invitrogen™ HBZ Polyclonal Antibody


Rabbit Polyclonal Antibody
Marca: Invitrogen™ PA542129
Este artículo no se puede devolver.
Vea la política de devoluciones
Descripción
Peptide sequence: ERLFLSHPQT KTYFPHFDLH PGSAQLRAHG SKVVAAVGDA VKSIDDIGGA Sequence homology: Cow: 93%; Goat: 93%; Horse: 86%; Human: 100%; Mouse: 85%; Pig: 93%; Rabbit: 92%; Rat: 93%.
This gene encodes a member of a subfamily of lipid trafficking proteins that are characterized by a C-terminal steroidogenic acute regulatory domain and an N-terminal metastatic lymph node 64 domain. The encoded protein localizes to the membranes of late endosomes and may be involved in exporting cholesterol. Alternative splicing results in multiple transcript variants.
Especificaciones
| HBZ | |
| Polyclonal | |
| Unconjugated | |
| Hbz | |
| AI450015; alpha-like embryonic globin chain x; Hba-x; HBAZ; HBZ; HBZ1; HBZ2; HBZ-T1; hemaglobin zeta; hemoglobin subunit zeta; hemoglobin X, alpha-like embryonic chain in Hba complex; Hemoglobin zeta; hemoglobin zeta chain; hemoglobin, zeta; RA_M008_JSM295ECF; RGD1307486; zeta globin; zeta-globin | |
| Rabbit | |
| Protein A | |
| RUO | |
| 3050 | |
| -20°C, Avoid Freeze/Thaw Cycles | |
| Liquid |
| Immunohistochemistry (Paraffin), Western Blot | |
| 1 mg/mL | |
| PBS with 2% sucrose and 0.09% sodium azide | |
| P02008 | |
| Hbz | |
| Synthetic peptide directed towards the N-terminal of human HBZ (aa 31-80). | |
| 100 μL | |
| Primary | |
| Human | |
| Antibody | |
| IgG |
Corrección del contenido de un producto
Proporcione sus comentarios sobre el contenido del producto rellenando el siguiente formulario.
Título del producto
¿Detecta una oportunidad de mejora?Comparta una corrección de contenido